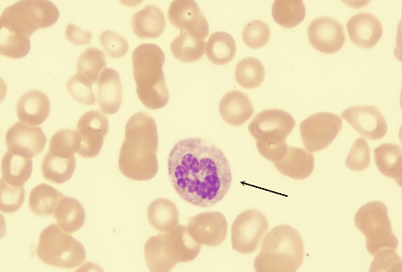
巨幼细胞性贫血的治疗

贫血的种类有很多,不同的病因会出现不同类型的贫血,巨幼细胞性贫血主要是由于人体内维生素B12及叶酸的缺少所导致的,如果出现以下症状,就应该警惕巨幼细胞性贫血,巨幼细胞性贫血会引发很多并发症,严重的话还会危及生命,所以一定要留意巨幼细胞性贫血的症状。

巨幼细胞性贫血症状
1、一般临床表现
(1)贫血:贫血起病隐匿,特别是维生素B12缺乏者常需数月。而叶酸由于体内储存量少,可较快出现缺乏。某些接触氧化亚氮者、ICU病房或血液透析的患者,以及妊娠妇女可在短期内出现缺乏,临床上一般表现为中度至重度贫血,除贫血的症状如乏力、头晕、活动后气短心悸外,严重贫血者可有轻度黄疸,可同时有白细胞数和血小板减少,患者偶有感染及出血倾向
(2)胃肠道症状:胃肠道症状表现为反复发作的舌炎,舌面光滑、乳突及味觉消失、食欲不振。腹胀、腹泻及便秘偶见。
(3)神经系统症状:维生素B12缺乏特别是恶性贫血的患者常有神经系统症状,主要是由于脊髓后、侧索和周围神经受损所致。表现为乏力、手足对称性麻木、感觉障碍、下肢步态不稳、行走困难。小儿及老年人常表现脑神经受损的精神异常、无欲、抑郁、嗜睡或精神错乱。部分巨幼细胞贫血患者的神经系统症状可发生于贫血之前。
上述三组症状在巨幼细胞贫血患者中可同时存在也可单独发生,同时存在时其严重程度也可不一致。
2、特殊类型临床症状表现
(1)热带口炎性腹泻:这种疾病,也叫热带营养性巨幼细胞贫血,病因不清楚。多见于印度东南亚、中美洲以及中东等热带地区的居民和旅游者。临床症状与麦胶肠病相似。血清叶酸及红细胞叶酸水平降低、用叶酸治疗加广谱抗生素能使症状缓解及贫血纠正。缓解后应用小剂量叶酸维持治疗以防止复发。
(2)乳清酸尿症:乳清酸尿症是一种遗传性嘧啶代谢异常的疾病,除有巨幼细胞贫血外尚有智力低下及尿中出现乳清酸结晶。患者的血清叶酸或维生素B12的浓度并不低,用叶酸或维生素B12治疗无效,用尿嘧啶治疗可纠正贫血。
(3)恶性贫血:这是由于胃黏膜萎缩、胃液中缺乏内因子,所以无法吸收维生素B12而发生的巨幼细胞贫血发病机制,似与种族和遗传有关。

巨幼细胞性贫血的治疗
1、一般治疗
治疗基础疾病,去除病因。加强营养知识教育纠正偏食及不良的烹调习惯。
2、补充叶酸或维生素B12
(1)叶酸缺乏 口服叶酸。胃肠道不能吸收者可肌肉注射四氢叶酸钙,直至血红蛋白恢复正常。一般不需维持治疗。
(2)维生素B12缺乏 肌肉注射维生素B12,直至血红蛋白恢复正常。恶性贫血或胃全部切除者需终生采用维持治疗。维生素B12缺乏伴有神经症状者对治疗的反应不一,有时需大剂量、长时间(半年以上)的治疗。对于单纯维生素B12缺乏的患者,不宜单用叶酸治疗否则会加重维生素B12的缺乏,特别是要警惕会有神经系统症状的发生或加重。
(3)严重的巨幼细胞贫血 患者在补充治疗后要警惕低血钾症的发生。因为在贫血恢复的过程中,大量血钾进入新生成的细胞内,会突然出现低钾血症,对老年患者和有心血管疾患、纳差者应特别注意及时补充钾盐。
温馨提示:不好的饮食习惯,不健康的生活习惯,不良的作息,都会导致很多疾病的出现,所以预防多种疾病,应该从改善生活做起。